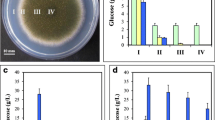

Abstract
For citric acid-accumulating Aspergillus niger cells, the enhancement of anaplerotic reactions replenishing tricarboxylic acid cycle intermediates predisposes the cells to form the product. However, there is no increased citrate level in germinating spores and a complex sequence of developmental events is needed to change the metabolism in a way that leads to an increased level of tricarboxylic acid cycle intermediates in mycelia. A review of physiological events that cause such intracellular conditions, with the special emphasis on the discussion of hexose transport into the cells and regulation of primary metabolism, predominantly of glycolytic flux during the process, is presented.
Similar content being viewed by others
Avoid common mistakes on your manuscript.
Introduction
Aspergillus niger is an important industrial micro-organism. It is traditionally used for the production of citric acid but its use as a producer of commercially important enzymes of both homologous and heterologous origin has increased rapidly. Strain improvement and the optimisation of production media have resulted in a process of citric acid accumulation by which cells convert up to 80% of the substrate, sucrose, to the final product.
In nature, the growth of aspergilli is often on natural plant debris such as leaves or on fruit. Much plant material is low in free glucose and other sugars (less than 100 μmol) while fruits may contain up to 500 mmol sugar (Wrolstad and Shallenberger 1981). Similar high sugar levels are employed in the citric acid process. To cope with such a large variation in carbon source concentration, aspergilli and other fungi have developed a number of strategies, which are of most interest at the extremes of high and low sugar concentration.
In the second half of last century, progress in the life sciences and accumulating knowledge about metabolic events in the cells stimulated several research groups to study the biochemical basis of acid accumulation by A. niger. Although the metabolism in A. niger during this process has been reviewed recently (Wolschek and Kubicek 1999; Ruijter et al. 2002; Karaffa and Kubicek 2003), crucial developmental events in primary metabolism described since these reviews have enlarged our understanding of the process. The glucose uptake rate has been identified as an important factor in the rate of citric acid production by Torres (1994a, b) who used mathematical modelling to predict that the glycolytic reactions of A. niger are limited by the supply of the initial substrate and removal of the final product.
It is generally accepted that citric acid is excreted from A. niger cells in response to unfavourable intracellular conditions that lead to increased levels of tricarboxylic acids (TCA) through anaplerotic pathways during growth in a high sucrose concentration media, with initial concentration of 15% (w/v) or more. In A. niger such enhanced anaplerotic conditions were often reported (Kubicek and Röhr 1978; Legiša and Kidrič 1989; Peksel et al. 2002). Extensive studies have revealed that there are three main metabolic events that replenish tricarboxylic acid cycle intermediates and predispose the cells to product formation:
-
Fast uptake of glucose based on simple diffusion.
-
Unrestricted metabolic flow through glycolysis, making precursors for synthesis of TCA cycle intermediates readily available.
-
Uncoupled NADH re-oxidation resulting in lower levels of ATP and therefore decreased anabolic reactions.
In the present review, we will concentrate on those physiological events that cause enhanced anaplerotic conditions with special emphasis on the discussion of hexose transport into the cells and regulation of primary metabolism, predominantly of glycolytic flux, during the process.
Uptake of glucose based on passive diffusion
For citric acid fermentation, hexoses are normally used as a carbon source, since aspergilli grow well on glucose and fructose (Hondmann and Visser 1994). For industrial purposes sucrose, which is normally used, is hydrolysed to monomers during heat sterilisation at low pH values or by invertase during the germination of spores.
High affinity carriers
A high affinity glucose transporter has been reported in A. niger (Torres et al. 1996b) based on transport assays. The V max value, when assayed in mycelium grown in 1% glucose, was 130 nmol/min mg dry weight and a K m of 0.39 mmol which is about an order of magnitude lower than high affinity systems for other filamentous fungi. When grown in high glucose conditions the K m was similar (0.26 mmol) but the V max was smaller (around 44 nmol/min mg dry weight). The carrier is inhibited by citrate and by low pH.
A sugar transporter-encoding gene, mstA, has been cloned from a genomic DNA library of A. niger (vanKuyk et al. 2004). The gene is a member of the major facilitator superfamily (MFS) and, when expressed in a Saccharomyces cerevisiae strain deficient in hexose uptake, showed a K m of 25 ± 10 μmol. This transporter catalyses a monosaccharide/H+ exchange and is expressed in response to carbon starvation. It is also subject to CreA-mediated carbon catabolite repression and pH regulation mediated by the PacC transcription factor. The K m value is about 1000 times lower than the “high affinity” carrier previously described so the MstA transporter could be described as “very high affinity”. Its presence is consistent with the wide range of carbon concentrations that can be successfully utilised by A. niger, from virtually zero to a syrup of 15% (w/v). It is anticipated that other putative sugar transporters will be revealed by the genome sequence of A. niger.
Low affinity carriers
When grown on 15% (w/v) glucose, A. niger contains a low affinity carrier in addition to the high affinity carrier which is the sole carrier when glucose concentrations of 1% were used (Torres et al. 1996a). Although both carriers showed decreased activity at low pH and inhibition by citrate, this was less pronounced for the low affinity carrier.
The low affinity system showed lower affinity (K m 3.67 mmol against K m 0.26 mmol for the high affinity carrier) and smaller V max (121 nmol/min.mg dry weight—against 43 nmol/min mg dry weight) The authors considered the low affinity carrier was involved in the mechanism by which A. niger responds to high extracellular glucose concentrations leading to citric acid accumulation. Both these carriers appear to provide facilitated diffusion rather than active transport. Although the gene encoding the low affinity carrier from A. niger has not yet been characterised, an ortholog from A. nidulans was recently described (Forment et al. 2006). The expression of mstE gene was enhanced by glucose and was dependent on the function of the transcriptional regulator, CreA. The disruption of the gene resulted in the absence of low affinity glucose uptake kinetics. Detailed sequence analysis showed that the MstE transporter belongs to the Sugar Porter family of the Major Facilitator Superfamily (MFS). Automatic annotation of the A. nidulans genome data has assigned an additional 101 putative gene products to the “sugar (and other) transporter” family, and a similar situation is likely in A. niger. Only the understanding of the properties and function of all membrane proteins involved in sugar assimilation will provide a full understanding of carbohydrate uptake by filamentous fungi.
Facilitated diffusion versus simple diffusion
Both facilitated diffusion and active transport are characterised by a non-linear activity response to increasing substrate concentration, whereas simple diffusion has a linear response. Examination of the specific glucose uptake rate and glucose concentration for several citric acid producing systems, from shake flask, batch culture, air lift fermentors and chemostats showed clearly that the response of citric acid producing systems was linear (Fig. 1) and fitted a simple diffusion model and were far removed from the predictions of the facilitated diffusion models (Wayman and Mattey 2000). Further, the system showed no response to citric acid levels as would be expected from the involvement of the known carriers.
Results from the mediated transport and diffusion models, showing the effect of glucose concentration on the specific glucose uptake rate by Aspergillus niger (at pH 2 for the carrier system). The total uptake mediated by both the high and low-affinity carriers is shown by the dashed line and the uptake by simple diffusion is shown by the solid line. The median observed values for specific uptake rate from the glucostat experiments (◊) are also shown (from Wayman and Mattey 2000 with permission)
Regulation of glycolysis
In the past, physiological studies of A. niger during the process of citric acid accumulation were performed on highly excreting mycelium where strong anaplerotic reactions are well established. However, no citric acid could be detected in the medium up to 24 h of growth in a batch system (Legiša and Mattey 1986a), while a relatively slow excretion rate was recorded during the second day of fermentation followed by a sudden increase in specific productivity afterwards (Röhr and Kubicek 1981; Ruijter et al. 1997; Papagianni et al. 2005). During the early stages of growth of A. niger, abnormal spore germination was observed in a form of bulbous cells, while at approximately 24 h a sudden change in morphology occurred (Fig. 2). Highly branched filamentous hyphae were formed that represented the major part of biomass later responsible for acid overflow (Legiša et al. 1981).
Morphology of A. niger after 40 h of growth in high citric acid yielding medium. Filamentous hyphae (left) emerge from enlarged bulbous cells (right) after approximately 24 h of growth (from Legiša et al. 1981 with permission). Scale bar (bottom right) represents 10 μm
During the germination of spores flux distribution studies indicate that the pentose phosphate (PP) pathway is predominant followed by a switch to glycolysis before onset of citric acid excretion (Legiša and Mattey 1986b; Röhr et al. 1987). Initial phases of growth are characterised also by polyol formation and glucosamine accumulation. Quantitative balances show that more hexoses are taken up than can be accounted for by the production of biomass, CO2 and citrate in the first stage of fermentation, while during the later phase more citrate is excreted than sugar uptake would theoretically allow. Transient aminosugar accumulation in the medium is responsible for part of this effect (Papagianni et al. 2005), while an intermediate accumulation and later partial re-consumption of a number of polyols (glycerol, arabitol, erythritol, mannitol) contributes to the phenomenon as well (Röhr et al. 1987). For polyol formation there are strong indications that they are mostly synthesised from the intermediates of the PP pathway (Legiša and Mattey 1986b; Röhr et al. 1987; Hondmann and Visser 1994). Polyols, especially glycerol, whose intracellular concentration can reach up to 175 mmol, may play an important role as an osmoregulators in A. niger cells during the growth in high sucrose concentration media (Legiša and Kidrič 1989).
The direct conversion of hexoses to pyruvate via glycolysis becomes predominant during the productive phase of citric acid accumulation that starts after about 24 h and accelerates after 40–50 h of growth in a batch system (Legiša and Mattey 1986b). However the mechanism causing the shift of glucose degradation from PP pathway to glycolysis is not yet fully understood.
Regulation of the central part of hexose metabolism takes place at several levels: at the transcriptional level, by regulating the activity of allosteric enzymes by specific effectors and as suggested recently (Mesojednik and Legiša 2005; Mlakar and Legiša 2006), even by post-translational modification.
The studies of expression of genes encoding glycolytic regulatory enzymes showed that synthesis of hexokinase, glucokinase and pyruvate kinase was stimulated by a transfer of the mycelium to media with various carbon sources, with glucose and fructose having the most pronounced effect on triggering transcription. However, the presence of a metabolisable carbon source was found not to be sufficient and active carbon metabolism was required for expression of hexokinase and glucokinase genes in A. niger as well (Panneman et al. 1998).
Hexokinase and glucokinase
The hexose phosphorylation step is catalysed by two enzymes in A. niger: by hexokinase (EC 2.7.1.1.) and glucokinase (EC 2.7.1.2). The genes for both enzymes have been isolated and characterised as well as kinetics parameters determined (Panneman et al. 1996, 1998). Both genes are expressed constitutively under the conditions of active carbon metabolism but much wider substrate specificity was observed with hexokinase than with glucokinase. Although fructose could, in theory, be phosphorylated by glucokinase, relatively low affinity for fructose (K m 120 mmol) was measured, indicating that phosphorylation of fructose by glucokinase is negligible in A. niger cells. Glucokinase is relatively resistant to inhibition by various effectors, with an exception of ADP (K i 2.7 mmol) but readily deactivated at slightly decreased pH values (Panneman et al. 1996). On the other hand hexokinase can phosphorylate a wider range of hexoses and no significant preference over glucose or fructose could be observed at low sugar concentrations (Panneman et al. 1998). The enzyme activity was maximal at pH 7.5 but only half of that value was detect at pH 6.0.
Hexokinase is strongly inhibited by trehalose 6-phosphate (K i 0.01 mmol) an intermediate of trehalose metabolism (Panneman et al. 1998). Intracellular trehalose 6-phosphate concentrations detected in NW131 strain at 48 h of growth were 0.16 mmol (Panneman et al. 1998), which is sufficient for inhibition of hexokinase in vivo. A surprisingly negligible effect of the disrupted trpS gene, encoding trehalose 6-phosphate synthase, was observed on the specific productivity of citric acid. Only a slightly increased excretion rate was detected in respect to parental strain and trpS multicopy transformant, suggesting a minor role of trehalose 6-phosphate as an inhibitor of hexokinase in controlling glycolytic flux (Arisan-Atac et al. 1996). In fact, trehalose 6-phosphate levels were detected in A. niger cells only at 48 h of fermentation (Panneman et al. 1998) but never at later stages when citrate excretion rate reaches its maximum.
Recent analyses of metabolic fluxes from glucose to trehalose predicted a reduction in flux ratio with virtually no trehalose formation detected at 120 h (Peksel et al. 2002). In a closely related fungus Aspergillus nidulans (Fillinger et al. 2001) and in Neurospora crassa, trehalose was detected in spores but was rapidly degraded upon induction of conidial germination (d’Enfert et al. 1999). It was proposed that neutral trehalases hydrolyse intracellular trehalose after being phosphorylated by cAMP-dependent protein kinase (PKA) (d’Enfert et al. 1999). A spontaneous increase in cAMP concentration was, indeed, recorded at the early stages of A. niger growth which might be triggered in some strains by a slight intracellular acidification (Gradišnik-Grapulin and Legiša 1997). Assimilation of trehalose and concomitantly trehalose 6-phosphate during the germination might release the inhibition over hexokinase, which finally contributes to a shift of glucose degradation from the PP pathway to glycolysis.
6-Phosphofructo-1-kinase
ATP-dependent 6-phosphofructo-1-kinase (Pfk1) (EC 2.7.1.11) is the second allosteric enzyme of glycolytic pathway that normally plays a crucial role in controlling metabolic flux in eukaryotes. It catalyses the second, essentially irreversible reaction of glycolysis, the phosphorylation of fructose 6-phosphate using Mg–ATP to form fructose 1,6-bisphosphate and releasing Mg–ADP. Six organic allosteric ligands either increase or decrease substrate binding affinity and concomitantly determine overall enzyme activity (Poorman et al. 1984). Pfk1 from A. niger cells was a subject of various studies (Habison et al. 1983; Schreferl et al. 1986; Arts et al. 1987; Legiša and Benčina 1994; Mesojednik and Legiša 2005; Mlakar and Legiša 2006). The enzyme attracted the interest of investigators, due to its ability to maintain a high glycolytic flux in spite of elevated intracellular concentrations of citrate, a well-known inhibitor of Pfk1, which was reported to reach concentrations between 4 mM (Röhr and Kubicek 1981) and 10 mM (Legiša and Kidrič 1989).
Lack of metabolic regulation at the Pfk1 level was confirmed also from the studies performed by 13C-NMR analysis, showing that the control of glycolysis during the cultivation of A. niger in a medium with high sugar concentration was at the level of glyceraldehyde 6-phosphate (Peksel et al. 2002).
Recently, another enzyme exhibiting Pfk1 activity was isolated from A. niger mycelium with molecular mass of 49 kDa. A fragment of identical size could be also obtained in vitro by the proteolytic cleavage of the native Pfk1 with proteinase K. During the proteolytic digestion of the native enzyme, its activity was lost after 1 h of incubation, but the activity re-established after phosphorylation of the fragment by adding catalytic subunit of PKA enzyme to the system (Fig. 3). The native enzyme, as a sole Pfk1 enzyme, could be isolated only from the early stages of growth on a minimal medium, while a 49 kDa fragment seemed to appear later and was activated concurrently with a sudden change in the growth rate. SDS-PAGE of sequential purifications of Pfk1 enzymes by affinity chromatography during the early stages of the fungal development suggested a spontaneous post-translational modification of the native Pfk1 in A. niger cells. The final proof of in vivo modification, the detection of the shorter fragment in an extract of rapidly quenched mycelium by Western blotting, has not yet been done, but it is unlikely that the two-stage modification, proteolytic cleavage followed by phosphorylation of the fragment by PKA, would take place during the disruption of the cells and further purification procedure. By measuring kinetic parameters, ATP proved to be a strong inhibitor of the short Pfk1 fragment, but the negative effect of ATP seemed to be suppressed by physiological concentrations of fructose 2,6-bisphosphate. The same effector significantly increased the V max and the affinity of the fragmented protein toward the substrate, while it does not affect the maximal velocity of the native protein (Mesojednik and Legiša 2005). In A. niger about 6 μmol of fructose 2,6-bisphosphate were detected under citric acid excreting conditions (Ruijter et al. 1997). The studies on fructose 2,6-bisphosphate formation showed that its synthesis is stimulated after the transfer of A. niger mycelium from low (1%) to high (14%) initial sucrose medium simultaneously with a rapid increase in cAMP level (Kubicek-Pranz et al. 1990). Whether A. niger 6-phospho-2-kinase (Pfk2) activity is induced after the phosphorylation by PKA, as in yeast cells (Francois et al. 1984) or cAMP independent activation system is involved, as described in N. crassa (Dumbrava and Pall 1987) remains unknown.
The activity of isolated native 6-phosphofructo-1-kinase (Pfk1) enzyme from A. niger cells subjected to proteinase K rapidly decreased. After addition of the serine protease inhibitor PMSF (1 mmol) and the catalytic subunit of cAMP-dependent protein kinase enzyme to the system (arrow) the activity gradually re-established. The activities were measured first with 0.1 mmol ATP, then ATP was added to the final concentration of 1 mmol and finally fructose 2,6-bisphosphate was introduced into the system to the value of 8 μmol. The initial substrate (fructose 6-phosphate) was at 8 mmol. The results showed different kinetic characteristics of the native Pfk1 enzyme and the shorter fragment (from Mesojednik and Legiša 2005 with permission)
Other Pfk1 stimulators, AMP and ammonium ions, increased the activity of the shorter fragment more intensely than the activity of the native protein, while citrate, a well known allosteric inhibitor of eukaryotic Pfk1 enzymes, showed moderate inhibition of the native enzyme, while no inhibition of the fragment could be observed by concentrations up to 10 mM (Mlakar and Legiša 2006).
On the basis of the results obtained so far it could be speculated that it is the post-translational modification that makes A. niger Pfk1 enzyme extremely efficient. Proteolytic cleavage of a part of the protein molecule, might leave the shorter fragment not only resistant to citrate inhibition but also more susceptible to the positive effects of some specific effectors (Table 1). However, the shorter fragment is inactive immediately after proteolytic cleavage and must be phosphorylated in order to regain activity (Legiša and Benčina 1994; Mesojednik and Legiša 2005). PKA is capable of carrying over the appropriate phosphorylation, which leads to the re-activation of 49 kDa fragment (Mesojednik and Legiša 2005). Kinases are normally under the tight control of specific regulatory subunits and cAMP induces PKA activity. In A. niger A60 a spontaneous increase in the concentration of cyclic AMP was recorded after 24 h of growth in a citrate yielding medium. Further analyses showed that the amount of cAMP formed depends on the initial concentration of sucrose in the medium. Under higher sucrose conditions, the cAMP peak appeared earlier and was higher, while in lower sucrose media a flattened peak was observed later in fermentation (Gradišnik-Grapulin and Legiša 1997).
A spontaneous increase in cyclic AMP concentration could be caused by intracellular acidification since a drop of intracellular pH is known to stimulate the RAS-adenylate cyclase signalling pathway in a number of fungal species, including S. cerevisiae (Thevelein and de Winde 1999). In the citrate accumulating strain (A60) grown in a high sucrose medium, intracellular acidification was indeed recorded at the early stages of growth (Legiša and Kidrič 1989; Jernejc and Legiša 2004) with uncontrolled oxygen levels during measurements, while in another A. niger strain (NW131) no change in cytoplasmic and vacuolar pH could be detected by P31 NMR technique during the growth of immobilised cells (Hesse et al. 2002). Significant differences in membrane H+-ATPase activities of both strains were described. In the A60 (NRRL 2270; ATCC 11 414) strain the activity of proton pumps was a quarter of that in A158 (CBS 120,49; N400), a strain, which is related to the NW131 strain (Jernejc and Legiša 2004). Moreover, under identical growth conditions, strain A158 extruded protons more rapidly into the medium when ammonium ions were used as a sole nitrogen source than the A60 strain, indicating that proton pumps of the latter strain perhaps cannot extrude all the protons that are released into the cytosol after initial increase in intracellular citric acid concentration and ammonium assimilation (Jernejc and Legiša 2004).
Citric acid, which can reach concentration up to 10 mmol in the cells (Legiša and Kidrič 1989), dissociates at neutral pH values (pK 3 = 5.4) releasing two protons. On the other hand under citric acid-accumulating conditions, ammonium salts are the preferred source of nitrogen. A. niger consumes ammonium very rapidly which is normally depleted from the medium between 40 and 50 h of fermentation, well before the fungus stops growing (Papagianni et al. 2005). The amount of protons excreted from the biomass appeared to be directly related to the initial ammonium concentration (Papagianni et al. 2005). Although ammonium ions are taken up by an uniport mechanism, after the incorporation of NH +4 ion as an amino group, two protons are released which must be pumped back to the medium by H+-ATPases in order to maintain electroneutrality in the cells. Stoichiometric modelling of the early stages of the fermentation revealed that ammonium ions combine with a carbon-containing metabolite inside the cells in a 1:1 ratio, to form an organic nitrogen compound, which is immediately excreted by the mycelium. The compound was shown to be glucosamine by HPLC (Papagianni et al. 2005). The maximal rate of proton extrusion was recorded only after the depletion of ammonium from the medium.
A. niger is well known for its strong extra- and intra-cellular proteolytic activity (van den Hombergh et al. 1997). Although proteases are normally strictly compartmentalised in the cells and are activated from their pre-pro forms only in the vacuoles, some leakage through the tonoplast into the cytosol must occur, since cleavage of the native Pfk1 enzyme takes place. In A. niger cells, increased protein degradation occurs under Mn2+-deficient conditions, which was also reflected by increased intracellular proteinase activities (Ma et al. 1985; Schreferl et al. 1986). For efficient citric acid fermentation, lack of trace metal ions, particularly Mn2+ from the medium, is of major importance. Much has been speculated in past about the principal physiological role of Mn2+ in citric acid overflow, which seem to affect metabolism on various levels (Karaffa and Kubicek 2003). Whether Mn2+ is somehow involved in increased cytosolic protease activities, and concomitantly on the post-translational modification of Pfk1, will have to await further investigation.
Pyruvate kinase
Although 6-phosphofructo-1-kinase is the most complex regulatory enzyme of glycolysis, pyruvate kinase (EC 2.7.1.40), catalyzing the third irreversible step of glucose consumption, normally controls the outflow from the pathway in eukaryotes. This final step yields ATP and pyruvate. The pkiA gene encoding pyruvate kinase from A. niger cells has been isolated and characterised showing that the enzyme monomer has a molecular weight of 58 kDa (de Graaff et al. 1992), while the studies of enzyme kinetics revealed the importance of fructose 1,6-bisphosphate as a stabilising factor that prevented deactivation of the enzyme during the purification process. Interestingly no inhibition by ATP, a normal negative effector of eukaryotic pyruvate kinases could be observed for the A. niger enzyme, moreover even slightly higher activities of the enzyme were reported at physiological concentrations of ATP in the presence of fructose 1,6-bisphosphate (Meixner-Monori et al. 1984).
Future perspectives
Several genomes of Aspergillus species have now been fully sequenced and the information published: A. fumigatus (Nierman et al. 2005), A. nidulans (Galagan et al. 2005), A. oryzae (Machida et al. 2005), while the information of several other genomes including A. niger will be released in near future. By combining the data from sequence analyses, biochemical and physiological information available for A. niger and related filamentous fungi, an in silico model of the central carbon metabolism of A. niger has been constructed (David et al. 2003). Application of the stoichiometric model for assessing the metabolic capacities of A. niger to produce metabolites will offer an indispensable tool for strain improvement by recombinant DNA techniques.
However, the studies of the development from spores into the productive mycelium and understanding physiological changes in that phase, as they were partially described in the present mini-review, might open a new dimension to strain optimisation.
The response of A. niger to external glucose concentration shows considerable sophistication. Carriers of appropriate affinity are utilised from very high through to low, and when simple diffusion provides more glucose that needed for maximum growth, the carriers appear to be downregulated and mechanisms to remove excess glucose are deployed. Because the carriers are not needed at high glucose concentrations there is no need to clone carriers when attempting to improve flux though pathways in A. niger.
On the basis of knowledge of A. niger physiology during citric acid accumulation it could be concluded that there is no specific bottleneck in primary metabolism that would slow down the rate of acid overflow. Theoretical analysis of metabolism predicted that simultaneous overexpression of seven enzymes would be required for significant increase in flux (Torres et al. 1996a), while moderate overexpression of two regulatory enzymes (6-phosphofructo-1-kinase and pyruvate kinase), either individually or simultaneously, had no effect on citric acid production (Ruijter et al. 1997). However, recent discoveries about the eventual post-translational modification of Pfk1 at the early stages of A. niger growth in a medium with high initial sucrose concentration (Mesojednik and Legiša 2005; Mlakar and Legiša 2006) put a new light on primary metabolism of the fungus.
Although the final proof for in vivo post-translational modification of Pfk1 is lacking, there are indications that the processing of the native Pfk1 into an active, shorter, fragment by post-translational modification represents a vital regulatory step in A. niger glycolysis to obtain maximal metabolic flux leading to strong anaplerosis. However, spontaneous enzyme modification seems to be rather complex process, which depends on various environmental factors. It may be possible to avoid this complexity and minimise the influence of growth conditions on the events, by inserting a truncated gene that would directly encode a shorter Pfk1 fragment of appropriate length. With some additional site specific mutagenesis the phosphorylation step could also be omitted, giving an enzyme that would be insensitive to crucial feed back controls over glycolysis in A. niger cells, as well as in the cells of other commercial micro-organisms.
References
Arisan-Atac I, Wolschek MF, Kubicek CP (1996) Trehalose 6-phosphate synthase A affects citrate accumulation by Aspergillus niger under conditions of high glycolytic flux. FEMS Microbiol Lett 140:77–83
Arts E, Kubicek CP, Röhr M (1987) Regulation of phosphofructokinase from Aspergillus niger: effect of fructose 2,6-bisphosphate on the action of citrate, ammonium ions and AMP. Microbiology 133:1195–1199
de Graaff L, van den Broeck H, Visser J (1992) Isolation and characterization of the Aspergillus niger pyruvate kinase gene. Curr Genet 22:21–27
d’Enfert C, Bonini BM, Zapella PD et al (1999) Neutral trehalases catalyse intracellular trehalose breakdown in the filamentous fungi Aspergillus nidulans and Neurospora crassa. Mol Microbiol 32:471–483
David H, Akesson M, Nielsen J (2003) Reconstruction of the central carbon metabolism of Aspergillus niger. Eur J Biochem 270:4243–4253
Dumbrava VA, Pall ML (1987) Regulation of fructose 2,6-bisphosphate levels in Neurospora crassa. Biochim Biophys Acta 925:210–217
Fillinger S, Chaveroche MK, van Dijck P et al (2001) Trehalose is required for the acquisition of tolerance to a variety of stresses in the filamentous fungus Aspergillus nidulans. Microbiology 147:1851–1862
Forment JV, Flipphi M, Ramon D et al (2006) Identification of the mstE gene encoding a glucose-inducible, low affinity glucose transporter in Aspergillus nidulans. J Biol Chem 281:8339–8346
Francois J, Van Schaftingen E, Hers HG (1984) The mechanism by which glucose increases fructose 2,6-bisphosphate concentration in Saccharomyces cerevisiae. A cyclic-AMP-dependent activation of phosphofructokinase 2. Eur J Biochem 145:187–193
Galagan JE, Calvo SE, Cuomo C et al (2005) Sequencing of Aspergillus nidulans and comparative analysis with A. fumigatus and A. oryzae. Nature 438:1105–1115
Gradišnik-Grapulin M, Legiša M (1997) A spontaneous change in the intracellular cyclic AMP level in Aspergillus niger is influenced by the sucrose concentration in the medium and by light. Appl Environ Microbiol 63:2844–2849
Habison A, Kubicek CP, Röhr M (1983) Partial purification and regulatory properties of phosphofructokinase from Aspergillus niger. Biochem J 209:669–676
Hesse SJ, Ruijter GJG, Dijkema C et al (2002) Intracellular pH homeostasis in the filamentous fungus Aspergillus niger. Eur J Biochem 269:3485–3494
Hondmann DHA, Visser J (1994) Carbon metabolism. In: Martinelli SD, Kinghorn JR (eds) Aspergillus: 50 years on, progress in industrial microbiology, vol 29. Elsevier, Amsterdam, pp59–139
Jernejc K, Legiša M (2004) A drop of intracellular pH stimulates citric acid accumulation by some strains of Aspergillus niger. J Biotechnol 112:289–297
Karaffa L, Kubicek CP (2003) Aspergillus niger citric acid accumulation: do we understand this well working black box? Appl Microbiol Biotechnol 61:189–196
Kubicek CP, Röhr M (1978) The role of the tricarboxylic acid cycle in citric acid accumulation by Aspergillus niger. Eur J Appl Microbiol Biotechnol 5:263–271
Kubicek-Pranz EM, Mozelt M, Röhr M et al (1990) Changes in the concentration of fructose 2,6-bisphosphate in Aspergillus niger during stimulation of acidogenesis by elevated sucrose concentration. Biochim Biophys Acta 1033:250–255
Legiša M, Benčina M (1994) Evidence for the activation of 6-phosphofructo-1-kinase by cAMP-dependent protein kinase in Aspergillus niger. FEMS Microbiol Lett 118:327–333
Legiša M, Cimerman A, Sterle M (1981) Germination of Aspergillus niger in a high citric acid yielding medium. FEMS Microbiol Lett 11:149–152
Legiša M, Kidrič J (1989) Initiation of citric acid accumulation in the early stages of Aspergillus niger growth. Appl Microbiol Biotechnol 31:453–457
Legiša M, Mattey M (1986a) Glycerol as an initiator of citric acid accumulation in Aspergillus niger. Enzyme Microb Technol 8:258–259
Legiša M, Mattey M (1986b) Glycerol synthesis by Aspergillus niger under citric acid accumulating conditions. Enzyme Microb Technol 8:607–609
Ma H, Kubicek CP, Röhr M (1985) Metabolic effects of manganese deficiency in Aspergillus niger: evidence for increased protein degradation. Arch Microbiol 141:266–268
Machida M, Asai K, Sano M et al (2005) Genome sequencing and analysis of Aspergillus oryzae. Nature 438:1157–1161
Meixner-Monori B, Kubicek CP, Röhr M (1984) Pyruvate kinase from Aspergillus niger: a regulatory enzyme in glycolysis? Can J Microbiol 30:16–22
Mesojednik S, Legiša M (2005) Post-translational modification of 6-phosphofructo-1-kinase in Aspergillus niger. Appl Environ Microbiol 71:1425–1432
Mlakar T, Legiša M (2006) Citrate inhibition resistant from of 6-phosphofructo-1-kinase from Aspergillus niger. Appl Environ Microbiol 72:4515–4521
Nierman WC, Pain A, Anderson MJ et al (2005) Genomic sequence of the pathogenic and allergenic filamentous fungus Aspergillus fumigatus. Nature 438:1151–1156
Panneman H, Ruijter GJG, van den Broeck HC et al (1998) Cloning and biochemical characterisation of Aspergillus niger hexokinase—the enzyme is strongly inhibited by physiological concentrations of trehalose 6-phosphate. Eur J Biochem 258:223–232
Panneman H, Ruijter GJG, van den Broeck HC et al (1996) Cloning and biochemical characterisation of an Aspergillus niger glucokinase. Evidence for the presence of separate glucokinase and hexokinase enzymes. Eur J Biochem 240:518–525
Papagianni M, Wayman F, Mattey M (2005). Fate and role of ammonium ions during fermentation of citric acid by Aspergillus niger. Appl Environ Microbiol 71:7178–7186
Peksel A, Torres NV, Liu J et al (2002) 13C-NMR analysis of glucose metabolism during citric acid production by Aspergillus niger. Appl Microbiol Biotechnol 58:157–163
Poorman RA, Randolph A, Kemp RG et al (1984) Evolution of phosphofructokinase-gene duplication and creation of new effector sites. Nature 309:467–469
Röhr M, Kubicek CP (1981) Regulatory aspects of citric acid fermentation by Aspergillus niger. Process Biochem 16:34–37
Röhr M, Kubicek CP, Zehentgruber O et al (1987) Accumulation and partial re-consumption of polyols during citric acid fermentation by Aspergillus niger. Appl Microbiol Biotechnol 27:235–239
Ruijter GJG, Kubicek CP, Visser J (2002) Production of organic acids by fungi. In: Osiewacz HD (ed) The mycota X industrial applications, Springer-Verlag, Berlin, Heidelberg, New York
Ruijter GJG, Panneman H, Visser J (1997) Overexpression of phosphofructokinase and pyruvate kinase in citric acid-producing Aspergillus niger. Biochim Biophys Acta 1334:317–326
Schreferl G, Kubicek CP, Röhr M (1986) Inhibition of citric acid accumulation by manganese ions in Aspergillus niger mutants with reduced citrate control of phosphofructokinase. J Bacteriol 165:1019–1022
Thevelein JM, de Winde JH (1999) Novel sensing mechanisms and targets for the cAMP-protein kinase. A pathway in the yeast Saccharomyces cerevisiae. Mol Microbiol 33:904–918
Torres NV (1994a) Modelling approach to control of carbohydrate metabolism during citric acid accumulation by Aspergillus niger: I. Model definition and stability of steady state. Biotechnol Bioeng 44:104–111
Torres NV (1994b) Modelling approach to control of carbohydrate metabolism during citric acid accumulation by Aspergillus niger: II. Sensitivity analysis. Biotechnol Bioeng 44:112–118
Torres NV, Voit EO, Gonzalez-Alcon C (1996a) Optimization of nonlinear biotechnological process with linear programming: application to citric acid production by Aspergillus niger. Biotechnol Bioeng 49:247–258
Torres NV, Riol-Cimas JM, Wolschek M et al (1996b) Glucose transport by Aspergillus niger: the low affinity carrier is only formed during growth on high glucose concentrations. Appl Microbiol Biotechnol 44:790–794
van den Hombergh JP, van de Vondervoort PJ, Fraissinet-Tachet L et al (1997) Aspergillus as a host for heterologous protein production: the problem of proteases. Trends Biotechnol 15:256–263
vanKuyk PA, Diderich JA, MacCabe AP et al (2004) Aspergillus niger mstA encodes a high-affinity sugar/H+ symporter which is regulated in response to extracellular pH. Biochem J 379:375–383
Wayman FM, Mattey M (2000) Simple diffusion is the primary mechanism for glucose uptake during the production phase of the Aspergillus niger citric acid process. Biotechnol Bioeng 67:451–456
Wolschek MF, Kubicek CP (1999) Biochemistry of citric acid accumulation by Aspergillus niger. In: Kristiansen B, Mattey M, Linden J (eds) Citric acid biotechnology, Taylor Francis Ltd., London
Wrolstad RE, Shallenberger RS (1981) Free sugars and sorbitol in fruits—a complication from the literature. J Assoc Anal Chem 64:91–103
Author information
Authors and Affiliations
Corresponding author
Rights and permissions
About this article
Cite this article
Legiša, M., Mattey, M. Changes in primary metabolism leading to citric acid overflow in Aspergillus niger . Biotechnol Lett 29, 181–190 (2007). https://doi.org/10.1007/s10529-006-9235-z
Received:
Revised:
Accepted:
Published:
Issue Date:
DOI: https://doi.org/10.1007/s10529-006-9235-z